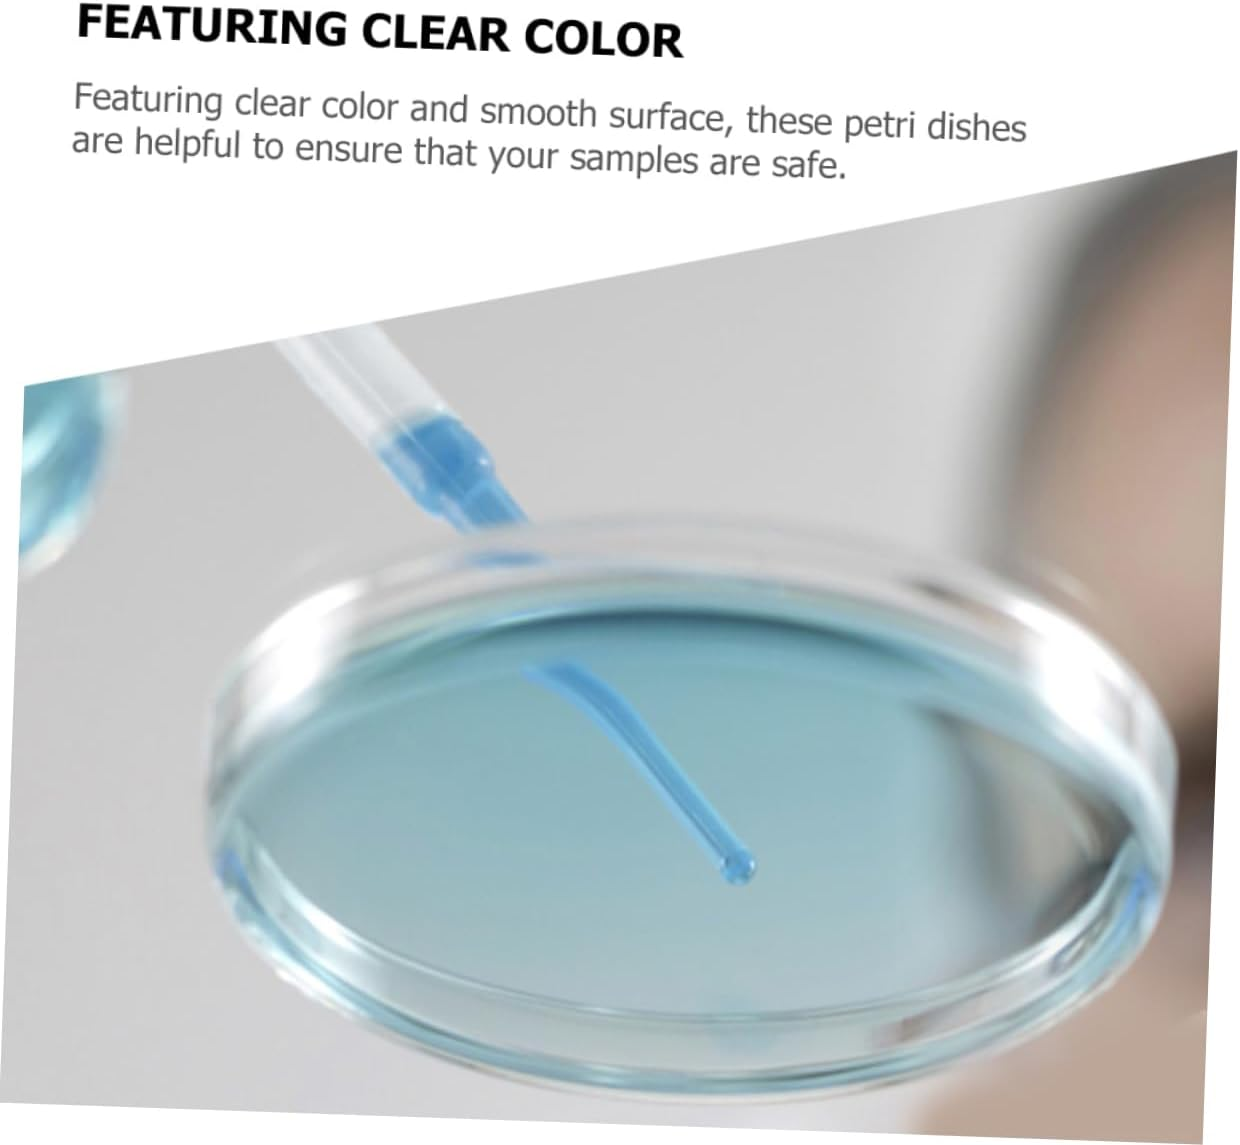
STOBOK 10Pcs Culture Plate Chemistry Petri Dish Science Petri Dishes Culture Dish Petri Dishes with Lid Culture Petri Dishes Tissue Culture Dish Plastic Reaction Plate with Cover image number 1
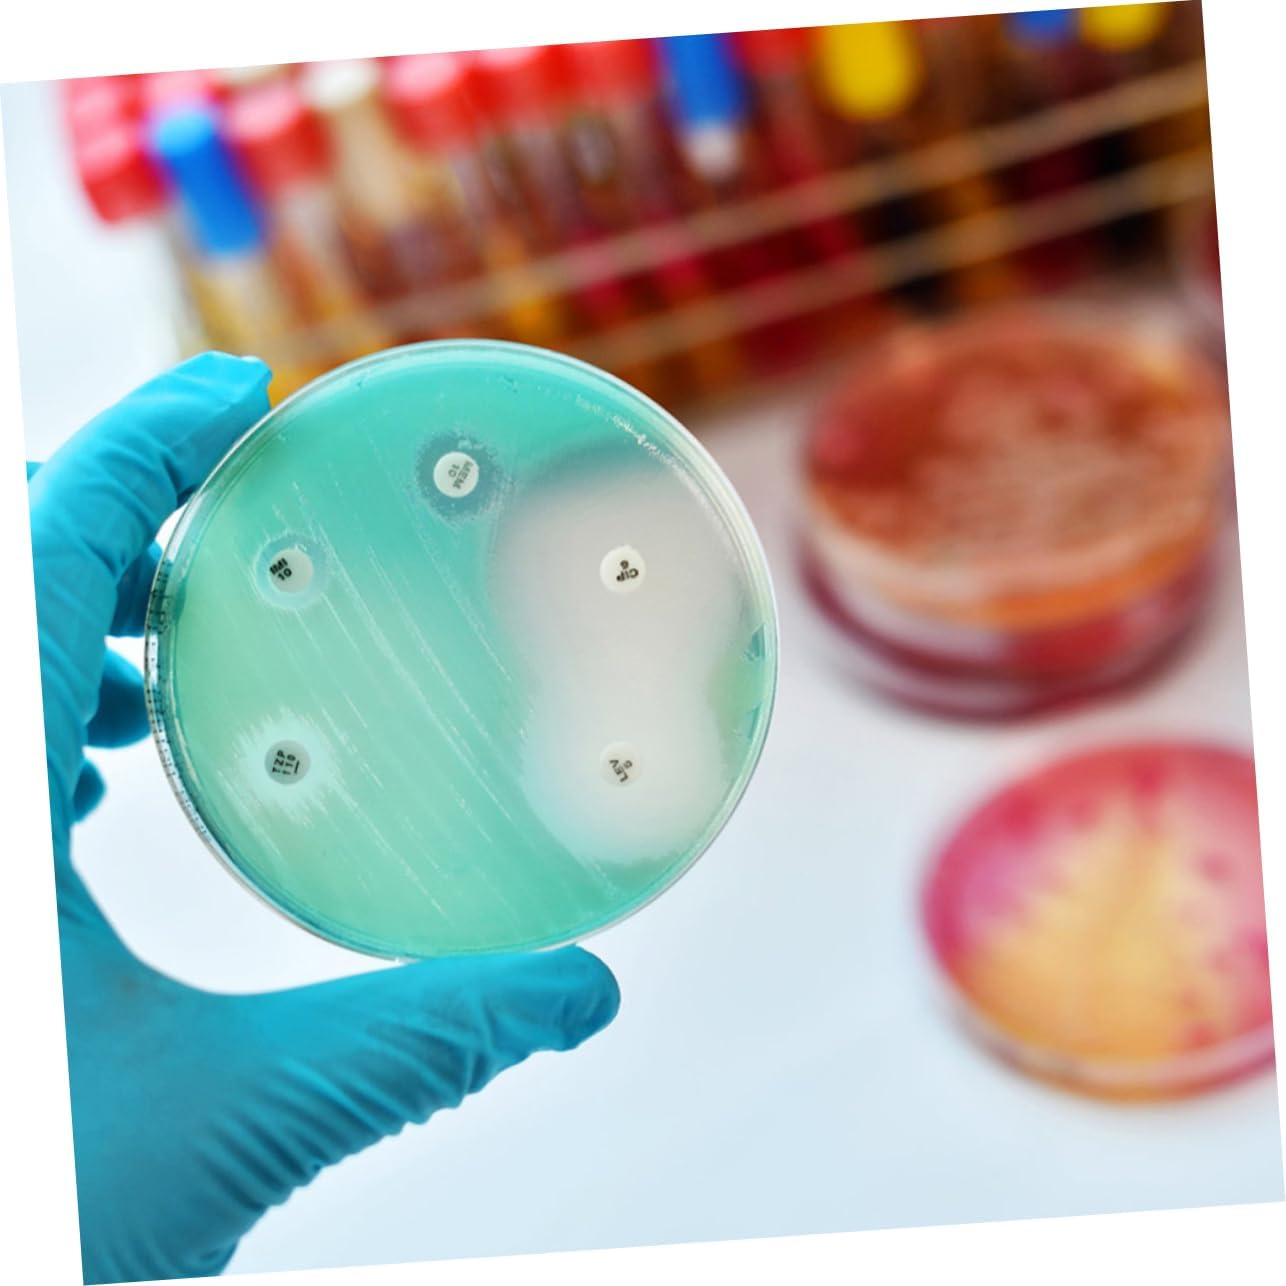
STOBOK 10Pcs Culture Plate Chemistry Petri Dish Science Petri Dishes Culture Dish Petri Dishes with Lid Culture Petri Dishes Tissue Culture Dish Plastic Reaction Plate with Cover image number 3
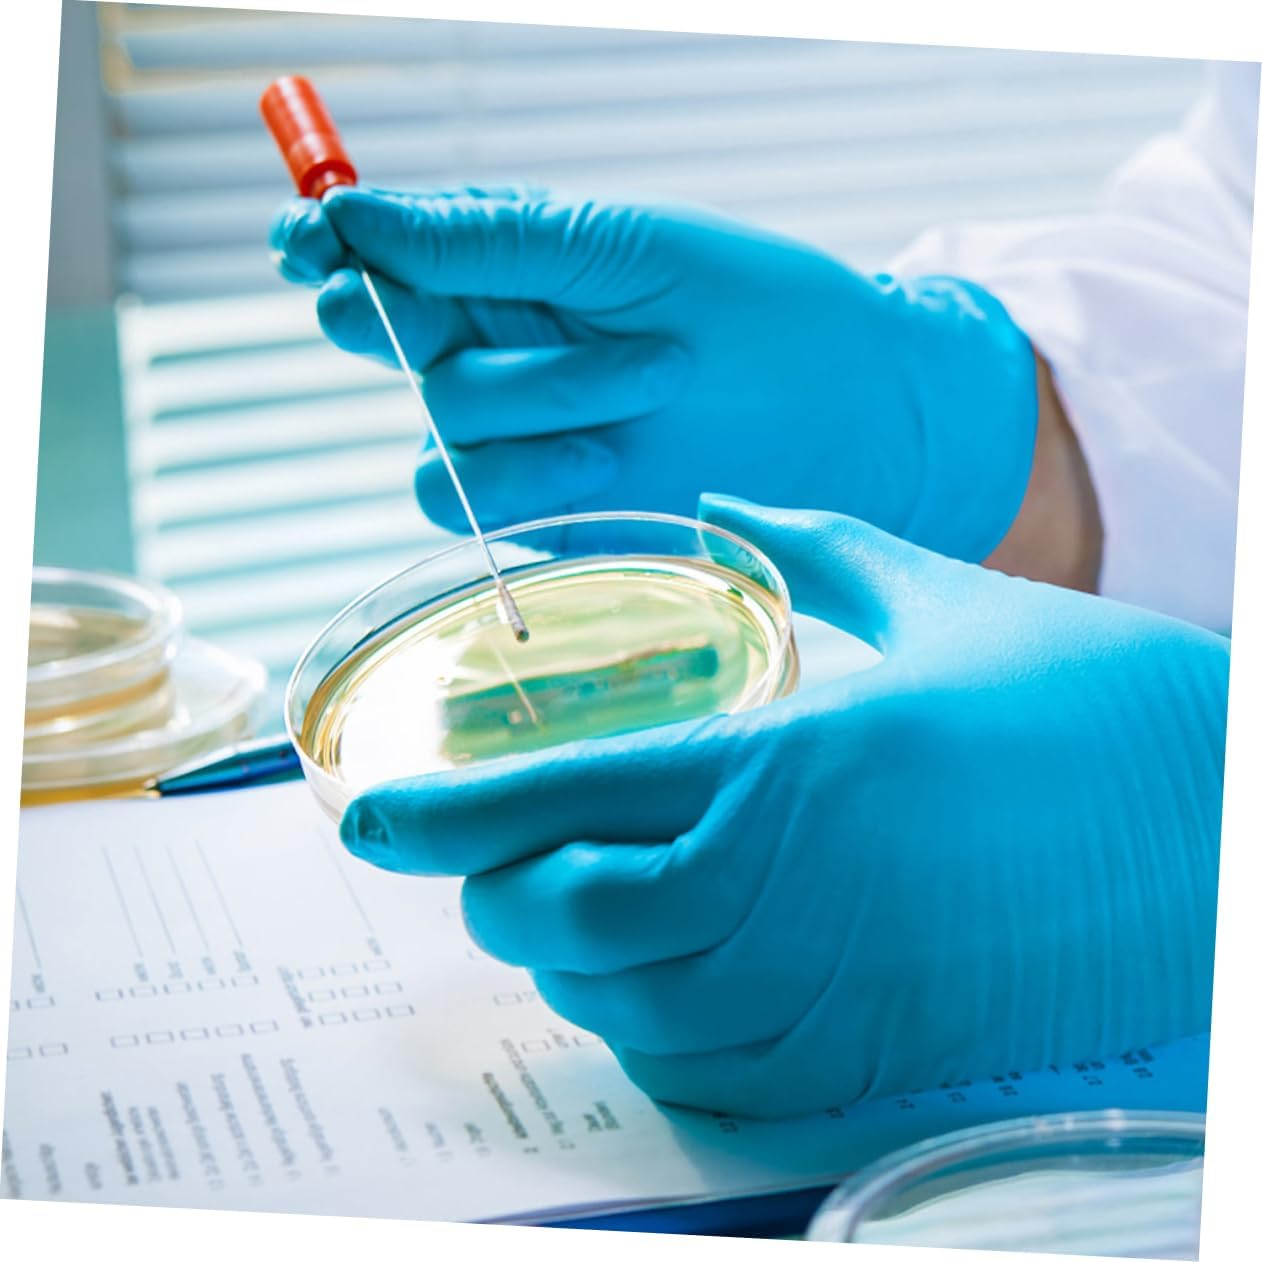
STOBOK 10Pcs Culture Plate Chemistry Petri Dish Science Petri Dishes Culture Dish Petri Dishes with Lid Culture Petri Dishes Tissue Culture Dish Plastic Reaction Plate with Cover image number 4
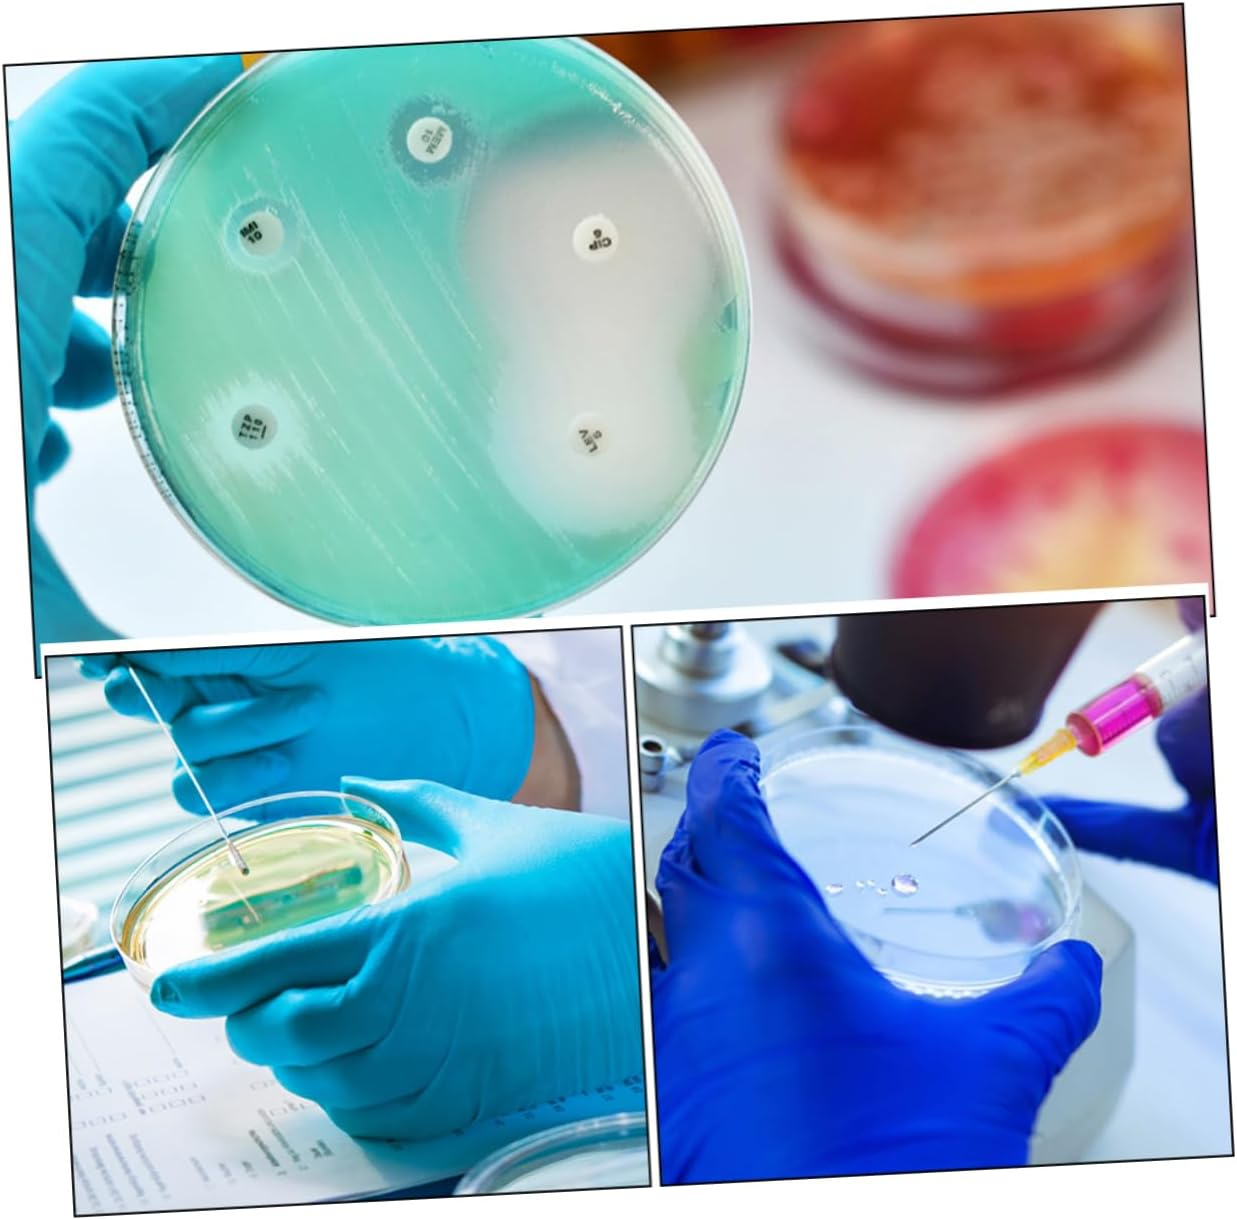
STOBOK 10Pcs Culture Plate Chemistry Petri Dish Science Petri Dishes Culture Dish Petri Dishes with Lid Culture Petri Dishes Tissue Culture Dish Plastic Reaction Plate with Cover image number 6

Free Shipping – Store Wide
STOBOK 10Pcs Culture Plate Chemistry Petri Dish Science Petri Dishes Culture Dish Petri Dishes with Lid Culture Petri Dishes Tissue Culture Dish Plastic Reaction Plate with Cover


STOBOK 10Pcs Culture Plate Chemistry Petri Dish Science Petri Dishes Culture Dish Petri Dishes with Lid Culture Petri Dishes Tissue Culture Dish Plastic Reaction Plate with Cover
Brand: STOBOK
A$7.05
- Culture dish: the cell culture plate is easy and simple to use, excellent and reliable, bring much convenience to your experiments
- Transparent Petri plates: The clear and transparent design of these petri dishes allows for easy observation of samples, making them ideal for scientific research and educational purposes
- Petri dishes with lids: suitable for any home, or laboratory use. enough quantity for you to use and replace.
- Tissue culture plate: this culture plate are suitable for researchers to do experiments, wonderful for cell culture use.
- Culture plate for lab: clear appearance and low expansion rate, moderate thickness, not easy to broke, practical and excellent.
Product Description
- Color: As Shown
- Size: Medium
lture dish: the cell ture plate is easy and simple to use, excellent and reliable, bring much convenience to you.
Petri plates: easy to observe with transparent and clear look design, and the bottom of the dish is flat and ooth.
lture dish: the cell ture plate is easy and simple to use, excellent and reliable, bring much convenience to you.
Petri plates: easy to observe with transparent and clear look design, and the bottom of the dish is flat and ooth.
Petri dishes with lids: suitable for any home, or laboratory use. enough quany for you to use and replace.
- Colour: As Shown
- Manufacturer reference: 4S1T02B7432SNYAEIEU38RHN
- Product dimensions: 3.5 x 3.5 x 1.5 cm; 0.03 Grams
- Manufacturer Part Number: 4S1T02B7432SNYAEIEU38RHN
- Size: medium
- Brand: STOBOK
- Manufacturer: STOBOK
A$7.05
Shipping to Australia
Delivery time varies by location
Return & Refund Policy
Check our return & refund policy
Security & Privacy
Safe payments: We do not share your personal details
Availability:
-
In Stock
Sign in
or create an eMega account
Shop smarter — get exclusive deals & order tracking